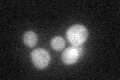
YKL189W
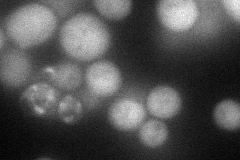
YKL189W
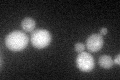
YKL189W
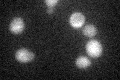
YKL189W

View description
Component of the RAM signaling network that is involved in regulation of Ace2p activity and cellular morphogenesis, interacts with Kic1p and Sog2p, localizes to sites of polarized growth during budding and during the mating response
Localization:
Intensity:
Fold change:
Significance:
-
C’ GFP library in SD
cytosol25.79 -
N' NOP1pr-GFP in SD
cytosol75.5032 -
N' TEF2pr-mCherry in SD

cytosol69.3938 -
N' NATIVEpr-GFP in SD

below threshold18.1359 -
N' TEF2pr-VC and Cyto-VN in SD

cytosol43.753 -
C’ GFP library in SD+DTT
cytosol25.951No -
C’ GFP library in SD+H2O2

cytosol28.511.1No -
C’ GFP library in Starvation Media
cytosol45.381.75No -
C’ GFP library on the background of Pup2-DaMP

cytosol -
C’ GFP library on the background of CCT mutant

cytosol25.92931.00522No
